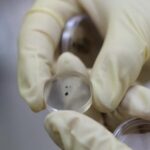
Chang_e_6_Moon_Samples_Confirm_Early__Magma_Ocean__Hypothesis

NASA’s Juno mission has unveiled groundbreaking insights into the volcanic activity of Jupiter’s moon Io, revealing that each of the moon’s volcanoes is powered by its own chamber of roiling hot magma rather than a global magma ocean. This discovery solves a 44-year-old mystery about the subsurface origins of Io’s most dramatic geological features.
Io, roughly the size of Earth’s moon, holds the title of the most volcanically active body in our solar system. Home to an estimated 400 volcanoes, Io’s surface is constantly reshaped by continuous eruptions that spew lava and plumes, contributing to its distinctive and dynamic landscape.
In December 2023 and February 2024, NASA’s Juno spacecraft made extremely close flybys of Io, coming within about 1,500 kilometers of its surface. During these close approaches, Juno communicated with NASA’s Deep Space Network, acquiring high-precision, dual-frequency Doppler data. This data was used to measure Io’s gravity by tracking how it affected the spacecraft’s acceleration, providing unprecedented insights into the moon’s interior structure.
The findings from these flybys have shed new light on the phenomenon of tidal flexing, where gravitational forces from Jupiter cause Io’s interior to flex and generate heat. “Juno’s discovery that tidal forces do not always create global magma oceans does more than prompt us to rethink what we know about Io’s interior,” said Ryan Park, a Juno co-investigator and supervisor of the Solar System Dynamics Group at NASA’s Jet Propulsion Laboratory.
“It has implications for our understanding of other moons, such as Enceladus and Europa, and even exoplanets and super-Earths. Our new findings provide an opportunity to rethink what we know about planetary formation and evolution,” Park added.
This revelation not only enhances our comprehension of Io but also offers valuable perspectives on the geological processes of other celestial bodies. By understanding that tidal forces can lead to localized magma chambers rather than global magma oceans, scientists can re-evaluate theories about planetary and moon formation both within our solar system and beyond.
Reference(s):
NASA's Juno mission uncovers heart of Jovian moon's volcanic rage
cgtn.com